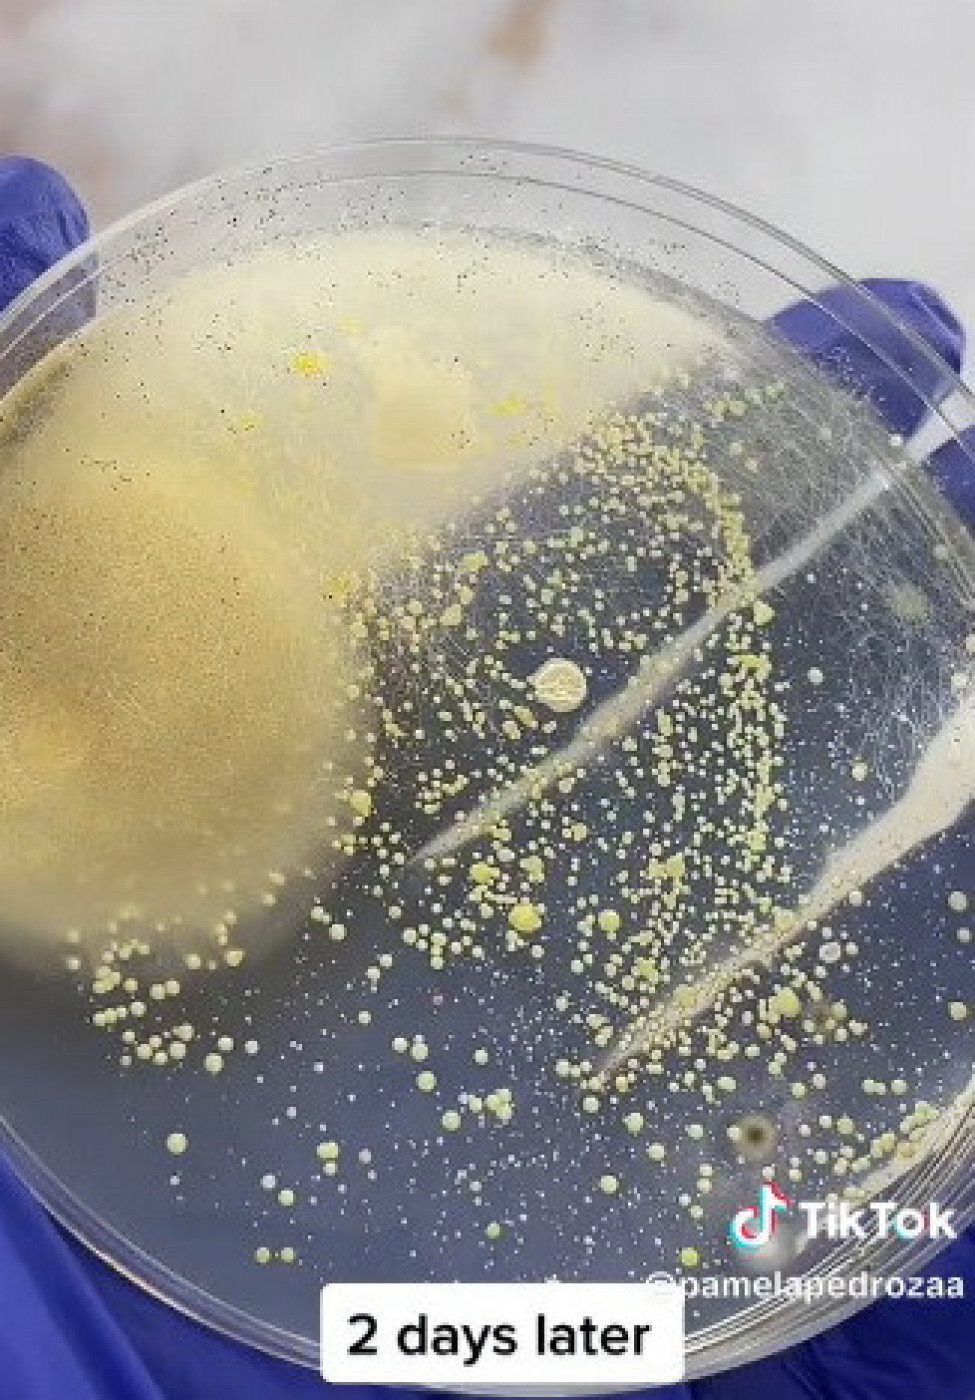

Šminka igra bitnu ulogu u životu većine žena, a sada više nego ikada pripadnice lepšeg pola vode računa o izgledu prateći trendove i sve što oni danas nameću. Shodno tome, ne postoji žena koja u svom neseseru nema pravi "arsenal" šminke koju možda toliko i ne koristi, ali se uvek tu nađe i neki komad viška, za svako slučaj.
Nekada smo puder nanosile rukama i uz nekoliko poteza, a novi trendovi i tutorijali za ulepšavanje, a koje svakodnevno gledamo, ponudili su nove proizvode i pribor koji će nam olakšati proces šminkanja. Jedan od njih je poznati bjuti blender pomoću kojeg nanosimo podloge za šminkanje i puder, korektor i konture. Sunđeraste je strukture i jajastog oblika i u radnjama ga možemo naći u najrazličitijim bojama.
Printscreen/TikTok/pamelapedrozaa
Iako izgleda prefinjeno u roze ili ljubičastoj boji, činjenica je da ovaj sunđerčić krije mnogo toga zabrinjavajućeg.
Ako je verovati snimku koji kruži TikTokom a postavila ga je Pamela Pedroza koja je isprobala eksperiment, čini se da bjuti blender u sebi sadrži mnoštvo bakterija. Ona je to pokazala jednostavnim testiranjem pomoću štapića za uši uz pomoć kojeg je prešla površinski po bjuti blenderu a onda pod mikroskpom pokazala šta se nalazi na njemu.
- Ako biste testirali moj bjuti blender našli biste čitav ekosistem - poručila je devojka, a onda su se na njen snimak nadovezali drugi korisnici Tiktoka i u komentarima pisali mišljenja o svemu što su videli.
- Praviću se da ovo nisam videla-
- Ovo je razlog zbog čega nanosim mejkap sveže opranih ruku -
- Ja perem jednom nedeljno blender.-
- Moj je definitivno užasan.- komentarisale su korisnice mreže.
Mnoge dame bile su zgrožene saznanjem da ovaj pribor za šminkanje sadrži sve te bakterije te su priznale da mu ne posvećuju posebnu pažnju kada je čišćenje u pitanju. Druge su se nadovezale da neće ni koristiti šminku ili da će je barem svesti na minimum.
Neke od korisnica su svima poručile da nakon svakog korišćenja moraju oprati sunđer dok su druge naglasile kako to čine često, jednom ili barem dva puta nedeljno.
Koliko god šminka bila zaštićena od prašine, činjenica je da se i na ovakvim stvarima sakupljaju bakterije i mikroorganizmi a naročito kada šminka dođe u dodir sa kožom na kojoj se takođe zadržava prašina i znoj koji okom nisu vidljivi. Da bi se izbegle ovakve situacije potrebno je redovno čistiti i dezinfikovati šminku, a pribor poput bjuti blendera i četki češće prati. Dovoljno je sapunom i toplom vodom.
Komentari (0)